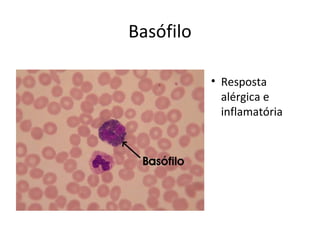
Basófilo
• Resposta
alérgica e
inflamatória
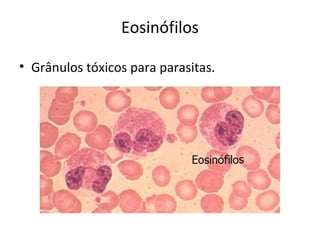
Eosinófilos
• Grânulos tóxicos para parasitas.

O documento aborda a hipersensibilidade tipo I, incluindo suas causas, mediadores e manifestações clínicas em cães e gatos, como a atopia. Destaca a resposta imune imediata, os sintomas de reações alérgicas e a ocorrência de choque anafilático. Além disso, menciona métodos de diagnóstico e referências bibliográficas relacionadas ao tema.